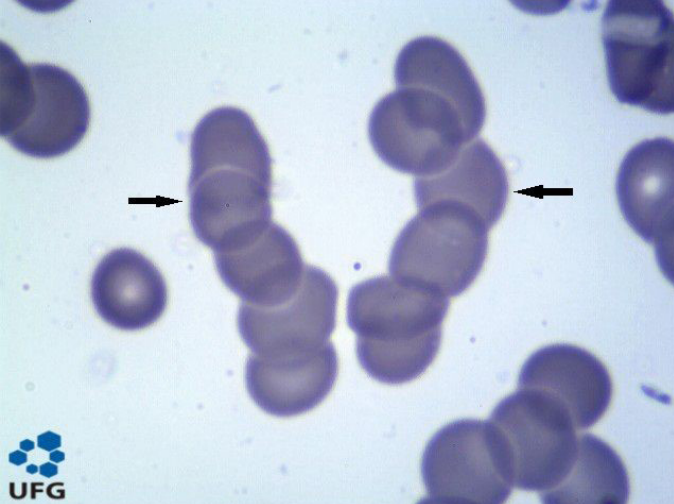

As discrasias plasmocitárias são um grupo de distúrbios caracterizados pela proliferação clonal de plasmócitos. Essa proliferação leva à produção de Proteína M. O espectro dessas doenças inclui condições como a Gamopatia Monoclonal de Significado Incerto (MGUS), o Mieloma Múltiplo, a Amiloidose AL e a Macroglobulinemia de Waldenström.
O que são as discrasias plasmocitárias?
As discrasias plasmocitárias compreendem um grupo de distúrbios caracterizados pela proliferação clonal de plasmócitos, que são células B ultra especializadas. Essa proliferação resulta na produção de uma proteína monoclonal (Proteína M), que é imunologicamente homogênea e disfuncional.
O método de triagem para essas condições é a eletroforese de proteínas séricas. Nela, a Proteína M se apresenta como um pico de base estreita na região das gamaglobulinas (pico monoclonal), diferentemente do aumento policlonal (visto em infecções, hepatopatias ou doenças autoimunes), que se manifesta como uma banda de base ampla.

Abaixo, detalhamos as principais entidades dentro desse espectro.
Gamopatia Monoclonal de Significado Incerto (MGUS)
A MGUS é a discrasia plasmocitária pré-maligna mais comum, não sendo considerada um câncer. É uma condição precursora que pode evoluir para Mieloma Múltiplo, Amiloidose AL ou Macroglobulinemia de Waldenström. Sua prevalência aumenta significativamente com a idade.
- Diagnóstico: É definido pela combinação de três critérios:
- Pico monoclonal < 3 g/dL.
- Infiltração de plasmócitos clonais na medula óssea < 10%.
- Ausência de lesões de órgão-alvo (critérios CRAB).
- Quadro Clínico: A MGUS é, por definição, assintomática.
- Manejo: Apresenta baixo risco de evolução, mas exige acompanhamento regular com hematologista.
Mieloma Múltiplo (MM)
O Mieloma Múltiplo é uma neoplasia hematológica caracterizada pela proliferação clonal de plasmócitos anômalos. O subtipo mais comum é o produtor de IgG. É uma doença mais frequente em idosos, com idade média ao diagnóstico entre 65 e 70 anos.
- Fisiopatologia e Clínica: A doença é definida pela presença de lesão de órgão-alvo, resumida pelo acrônimo CRAB:
- C: Hipercalcemia (Cálcio > 11 mg/dL).
- R: Insuficiência Renal (Creatinina > 2 mg/dL ou ClCr < 40 ml/min).
- A: Anemia (Hb < 10 g/dL).
- B: Lesões ósseas (“Bone”), que são tipicamente lesões líticas.

- Achados Adicionais: A principal causa de óbito é a infecção, devido à produção de imunoglobulinas disfuncionais. No sangue periférico, é comum o achado de hemácias em Rouleaux (empilhamento), causado pela perda do potencial ZETA da membrana pela deposição de imunoglobulinas.
- Diagnóstico: Requer a presença de >10% de plasmócitos na medula óssea (ou um plasmocitoma) associado a um ou mais dos critérios CRAB. O diagnóstico também pode ser fechado na ausência de CRAB se houver marcadores de alta carga tumoral (ex: >60% de plasmócitos na medula).
- Estadiamento: Utiliza o sistema R-ISS, que classifica o risco com base nos níveis de B2-microglobulina, albumina, LDH e a presença de alterações genéticas de alto risco por FISH.

Amiloidose Primária Sistêmica (AL)
A Amiloidose AL é uma discrasia plasmocitária onde o dano tecidual é causado pelo depósito sistêmico de fibrilas amiloides compostas por cadeias leves monoclonais. A cadeia leve lambda é a mais comumente envolvida.
- Quadro Clínico: É uma doença de envolvimento sistêmico, rápido e agressivo. As manifestações dependem do órgão-alvo:
- Rins: Proteinúria nefrótica (não diabética) e insuficiência renal.
- Coração: Miocardiopatia restritiva (responsável por 50% dos óbitos) e baixa voltagem no ECG.
- Sinais Clássicos: Macroglossia (aumento da língua) e Púrpura Periorbital (equimose ao redor dos olhos, “olhos de guaxinim”).

- Outros: Hepatoesplenomegalia, pneumopatia, polineuropatia e síndrome do túnel do carpo.
- Diagnóstico: O diagnóstico requer biópsia tecidual, sendo a gordura abdominal o sítio de eleição. A confirmação é feita pela coloração Vermelho do Congo positiva no tecido.
Síndrome POEMS
A POEMS é uma desordem plasmocitária rara, mais frequente após os 50 anos, cuja fisiopatologia envolve a superprodução de citocinas pró-inflamatórias, em especial o VEGF.
- Quadro Clínico: O nome é um acrônimo para suas principais manifestações:
- Polineuropatia.
- Organomegalia.
- Endocrinopatia.
- Proteína Monoclonal.
- Alterações de Pele (“Skin changes”).
- Diferencial: Diferente do Mieloma Múltiplo, as lesões ósseas na POEMS são tipicamente osteoescleróticas (e não líticas).
Macroglobulinemia de Waldenström (MW)
A MW é uma desordem linfoproliferativa (e não puramente plasmocitária) caracterizada pelo acúmulo da imunoglobulina monoclonal IgM.
- Fisiopatologia: A IgM é um pentâmero (uma molécula grande), e seu excesso leva à complicação mais temida: a Síndrome de Hiperviscosidade.
- Quadro Clínico: A hiperviscosidade é uma emergência médica. Causa alterações visuais, cefaleia, vertigem, nistagmo, ataxia e pode levar à descompensação de insuficiência cardíaca.
- Tratamento (da Hiperviscosidade): A medida de emergência é a Plasmaférese para remover o excesso de IgM. Deve-se evitar transfusões sanguíneas, pois elas podem aumentar ainda mais a viscosidade. O tratamento definitivo visa a doença de base.

Conquiste a aprovação e acompanhe mais conteúdos!
Gostou da novidade? Continue acompanhando nosso blog para ficar por dentro das principais notícias sobre residência médica, editais e oportunidades que podem transformar sua carreira!

